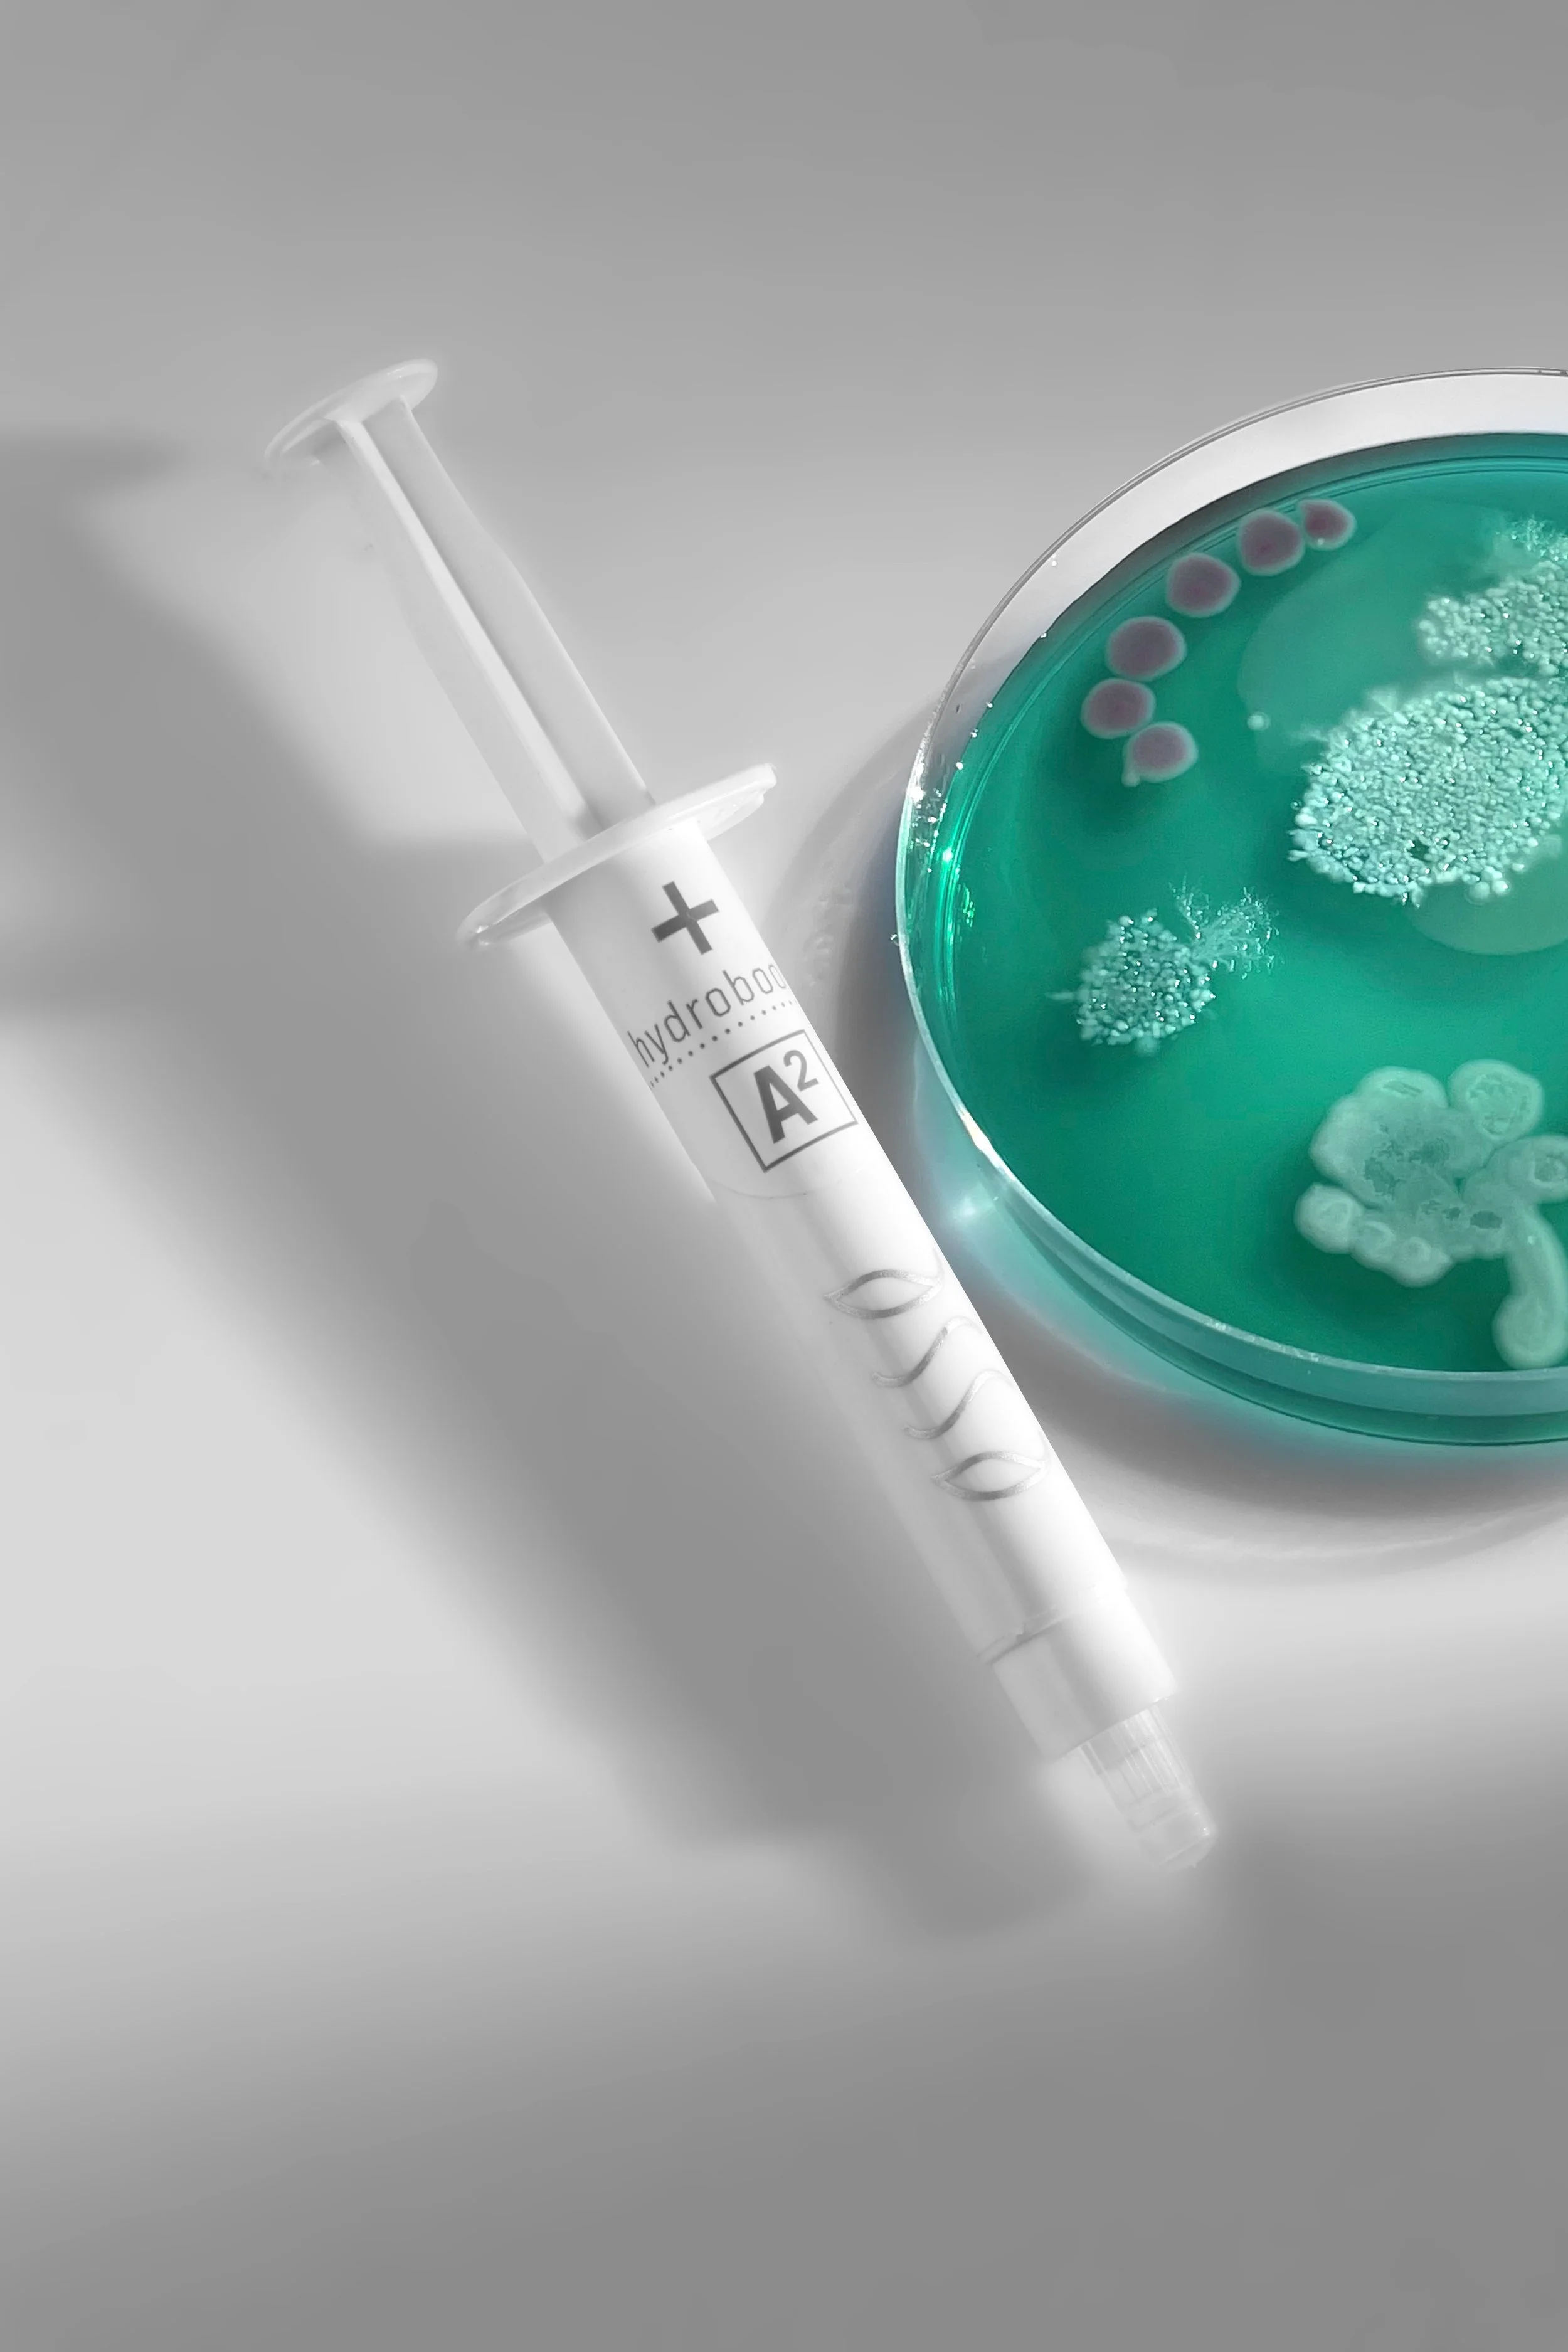

The ESSE Skin Philosophy
ESSE is a science-led, organic skincare brand that works with your skin’s natural microbiome to strengthen the barrier, calm inflammation and support long-term skin health. I chose ESSE because it aligns with my holistic approach — focusing on hormonal balance, sensitivity and ageing from the inside out, rather than quick fixes or harsh treatments.

Why I trust ESSE
After more than 10 years working in advanced skincare, I became increasingly aware that many modern products were focusing on quick results rather than long-term skin health. I wanted something different — a brand that supports the skin’s natural function, strengthens the barrier and works with the body rather than against it.
That’s why I chose ESSE.
ESSE combines organic, science-led skincare with a deep understanding of the skin microbiome. It aligns perfectly with my holistic approach, where we focus not just on the skin you see, but the underlying causes of inflammation, sensitivity and premature ageing.
-
Your skin is home to trillions of beneficial bacteria that protect, hydrate and strengthen it. This delicate ecosystem is known as the microbiome.
When the microbiome is balanced, your skin becomes:
• Stronger
• Calmer
• More resilient
• Less reactive
• More youthful
However, modern life can disrupt this balance. Stress, hormones, harsh skincare, over-exfoliation and environmental factors can all damage the skin barrier and increase inflammation.
This is why so many women experience sensitivity, breakouts and accelerated ageing — especially during perimenopause and menopause.
Restoring this balance is the foundation of healthy, glowing skin.
-
As hormones shift, the skin naturally becomes more fragile and reactive. Many women notice:
• Increased dryness
• Redness and sensitivity
• Hormonal breakouts
• Loss of glow
• Fine lines and dullness
Instead of aggressively treating symptoms, my approach focuses on calming inflammation and rebuilding the skin from within.
-
In my clinic, I use ESSE professional treatments designed to repair and rebalance the skin microbiome. These advanced probiotic facials help to:
• Strengthen the skin barrier
• Reduce inflammation
• Improve hydration and resilience
• Calm redness and sensitivity
• Support ageing skin
• Restore a healthy glow
For deeper results, I often recommend a structured Skin Reset journey, allowing the skin to heal over time.
-
Professional treatments are most effective when supported by the right homecare.
I carefully select and personalise ESSE routines for each client, focusing on simplicity, barrier repair and long-term skin health.
This approach is ideal for:
• Sensitive or reactive skin
• Hormonal or menopausal skin
• Acne and breakouts
• Rosacea
• Ageing and inflammation
Shop - Esse home skincare
-
I believe skin health is deeply connected to overall wellbeing. Hormones, nutrition, gut health, stress and lifestyle all influence how your skin looks and feels.
Alongside advanced treatments and skincare, I support clients with guidance on:
• Nutrition and blood sugar balance
• Hormones and menopause
• Stress and nervous system health
• Gut and skin connection
• Lifestyle and daily habits
This is where real, lasting change happens.
Calmer, Stronger, Healthier Skin
The following results shown come from consistency, barrier repair and personalised treatment plans, not harsh or aggressive approaches.






